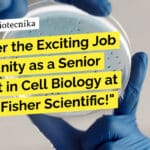
Discover the Exciting Job Opportunity as a Senior Scientist in Cell Biology at Thermo Fisher Scientific! "Discover the Exciting Job Opportunity as a Senior Scientist in Cell Biology at Thermo Fisher Scientific!"
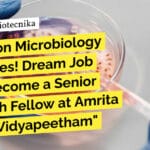
Attention Microbiology Graduates! Amrita Vishwa Vidyapeetham Hiring MSc For SRF Role "Attention Microbiology Graduates! Dream Job Alert: Become a Senior Research Fellow at Amrita Vishwa Vidyapeetham"

Home Search
biology - search results
If you're not happy with the results, please do another search
ICMR-NIV BSc MSc Biotechnology, Microbiology Project Job – Apply Online
ICMR-NIV BSc MSc Biotechnology, Microbiology Project Job - Apply Online
ICMR-National Institute of Virology, Bangalore Unit
Department of Health Research,
Ministry of Health & Family Welfare, Government...
THETA Cycle: A Breakthrough in Synthetic CO2 Conversion to Acetyl-CoA by Max-Planck-Institute for Terrestrial...
THETA Cycle: A Breakthrough in Synthetic CO2 Conversion to Acetyl-CoA by Max-Planck-Institute
Synthetic Carbon Dioxide Fixation in Living Cells
Synthetic biology has the potential to revolutionize...
Exciting Ph.D. Opportunities at India’s 1st Biotech University! Join Groundbreaking Research in Geomicrobiology and...
PhD at Gujarat Biotechnology University - Apply Online
Ph.D. opportunities in my Laboratory at Gujarat Biotechnology University (India's 1st Biotech University)
My laboratory (https://lnkd.in/dBWF-Ju6)] at Gujarat...
Piramal Hiring: Executive Regulatory Affairs Opportunity For MSc Life Sciences, Mol Bio, Biology, Biochem
Piramal Molecular Biology Executive Job - Regulatory Affairs Vacancy, Apply Online
Executive Regulatory Affairs
Company: Piramal
Location: Mumbai, Maharashtra, India
Job Description:
The incumbent will be responsible for reviewing...
Reliance Life Sciences Hiring! Biotech, Biochem & Microbiology Attend Walk-In
Reliance Life Sciences Hiring! Biotech, Biochem & Microbiology Walk-In
We welcome women returning to the workforce post a career break.
Reliance Life Sciences is a medical...
Calling All Biotech and Microbiology Experts! Reliance Life Sciences Walk-In Drive – Get Ready!
Reliance Life Sciences Walk-In Drive!
We are Hiring for Nashik and Navi Mumbai
Biosimilars
Welcome to Reliance Life Sciences Walk-In Drive! We are currently seeking qualified individuals...
Exciting Job Opportunity in Applied Biology and Biotech – Join ICMR-NIIH Research Team in...
ICMR-NIIH Applied Biology, Biotech, Life Sciences Research Recruitment
Indian Council of Medical Research (ICMR) - National Institute of Immunohaematology (NIIH)
The ICMR-NIIH in Mumbai is currently...
Discover the Exciting Job Opportunity as a Senior Scientist in Cell Biology at Thermo...
Thermo Fisher Cell Biology Scientist Job - MSc, PhD Life Sciences Apply
Senior Scientist I, Cell Biology
About Company:
Thermo Fisher Scientific Inc. is the world leader...
Attention Biotech, Biochem, and Microbiology Experts! Don’t Miss Out on Zydus Biologics QA Jobs...
Zydus Biologics QA Jobs For Biotech, Biochem, Microbiology - Attend Walk-In
Inviting candidates for Executive / Sr. Executive posts for
Zydus Biologics (Zydus Biotech Park), Ahmedabad...
Exciting Opportunity at University of Calcutta: Project Assistant Position in Environmental Science and Molecular...
University of Calcutta Recruitment - Molecular Biology Job
The University of Calcutta is seeking a qualified candidate for the position of Project Assistant. The project,...
Govt Chittaranjan National Cancer Institute MSc Medical Microbiology SRF Recruitment!
Govt CNCI MSc Job For Microbiology
Chittaranjan National Cancer Institute
(An Autonomous Institute under Ministry of Health and Family Welfare, Govt. of India)
2nd Campus - Street...
Attention Microbiology Graduates! Amrita Vishwa Vidyapeetham Hiring MSc For SRF Role
Amrita Vishwa Vidyapeetham Hiring! MSc Microbiology Apply For SRF Role!
Amrita Vishwa Vidyapeetham is a multi-disciplinary, research-intensive, private university, educating a vibrant student population of...
Attention Biology Enthusiasts! Novartis is Hiring Expert Curators to Revolutionize Drug Discovery – Apply...
Novartis Biology Curation Expert Recruitment, Apply Online
Role Title: Curation Expert
Location: Hyderabad
About the Role:
Novartis Institutes for BioMedical Research (NIBR) is the global pharmaceutical research organization...
Attention Biology Enthusiasts! Don’t Miss Out on this Exciting JRF Job at MAHE Manipal...
MAHE Manipal Genetics JRF - Biological Sciences Apply
Junior Research Fellow - Biological Sciences
Manipal Academy of Higher Education (MAHE) is now hiring for the position...
Get Your Dream Biology Job in Mumbai at dsm-firmenich – Apply Now!
Biology Jobs at dsm-firmenich - Regulatory Affairs Specialist
About dsm-firmenich
dsm-firmenich is a company that values diversity in the workplace and is committed to providing equal...